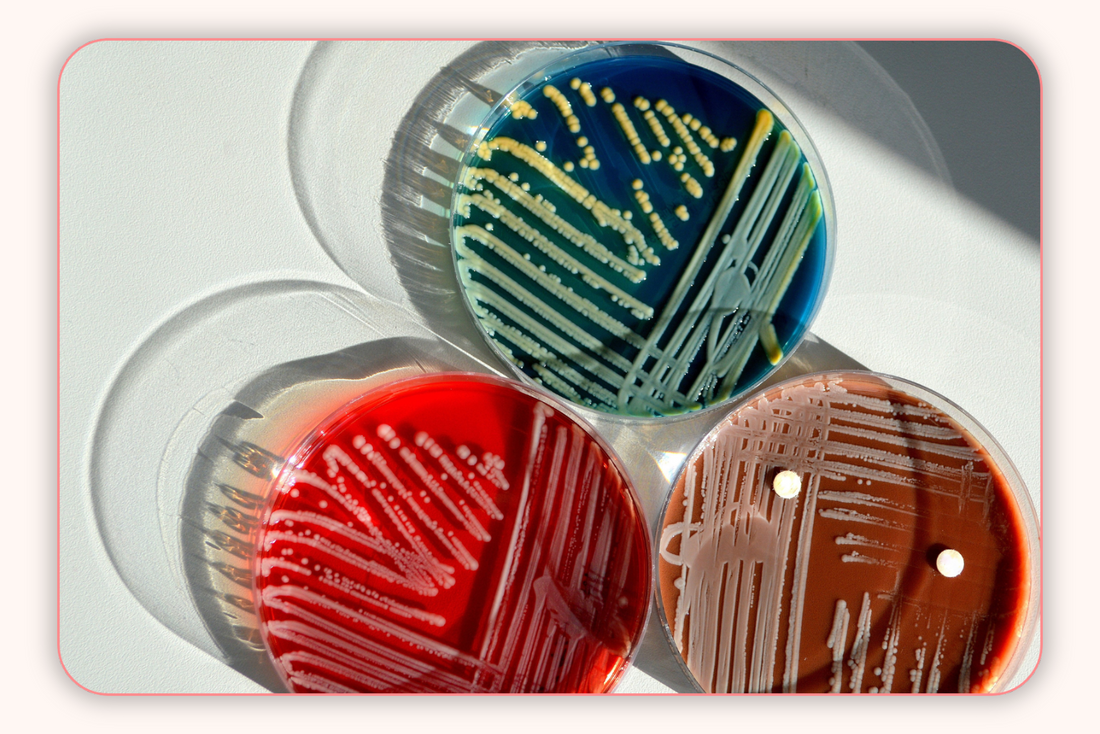
La vaginose bactérienne peut-elle causer la maladie inflammatoire pelvienne ?

La vaginose bactérienne peut-elle causer la maladie inflammatoire pelvienne ?
Introduction
La vaginose bactérienne (VB) et la maladie inflammatoire pelvienne (MIP) semblent, à première vue, peu liées. Pourtant, le corps humain est complexe, et des connexions inattendues entre ces affections peuvent exister. Quel est le lien entre la VB et la MIP, et que faire si vous développez l’une de ces conditions courantes ?
Qu’est-ce que la Vaginose Bactérienne ?
La VB est un type de vaginite (inflammation du vagin) qui affecte environ 21 millions de femmes aux États-Unis, bien que moins de la moitié des cas présentent des symptômes. (1)
Elle est causée par un déséquilibre des bactéries présentes dans le vagin. Si certaines bactéries sont normales, leur déséquilibre permet la prolifération de bactéries nocives, appelées bactéries anaérobies, entraînant une infection.
Symptômes de la VB
Environ 85 % des femmes atteintes de VB ne présentent aucun symptôme. Cependant, certaines manifestations peuvent inclure :
- Pertes vaginales anormales : Pertes grises, fines et aqueuses.
- Odeur vaginale anormale : Odeur désagréable ou de poisson.
- Changement de pH vaginal : Un pH anormalement élevé (>4,5).
- Brûlures ou irritations vaginales.
- Crampes abdominales.
Complications de la VB
- Complications pendant la grossesse : Risque accru de naissance prématurée ou de bébé de faible poids.
- Infections sexuellement transmissibles (IST) : Augmentation du risque de contracter le VIH, la chlamydia et la gonorrhée.
- Maladie inflammatoire pelvienne (MIP) : Certaines bactéries associées à la VB peuvent également causer des infections pelviennes.
Qu’est-ce que la Maladie Inflammatoire Pelvienne ?
La MIP est une infection de la partie supérieure du tractus génital féminin, touchant des organes comme l’utérus, les ovaires et les trompes de Fallope. Elle survient souvent lorsque des bactéries sexuellement transmissibles migrent vers ces organes.
Symptômes de la MIP
- Douleurs pelviennes légères ou modérées.
- Saignements vaginaux inhabituels.
- Douleur pendant les rapports sexuels.
- Pertes vaginales jaunes ou verdâtres.
- Mictions douloureuses.
- Nausées, fièvre et frissons.
Complications de la MIP
- Abcès tubo-ovarien.
- Infertilité tubaire.
- Grossesse extra-utérine.
- Douleurs pelviennes chroniques.
La VB Peut-elle Causer la MIP ?
Des recherches montrent que les bactéries associées à la VB, telles que Gardnerella vaginalis et Mycoplasma hominis, peuvent causer des problèmes de santé reproductive, comme l’endométrite (inflammation de la paroi utérine) et la salpingite (inflammation des trompes de Fallope). Ces conditions sont directement liées à la MIP.
Lorsque les niveaux de Lactobacillus (bactéries bénéfiques) sont faibles, le vagin devient vulnérable à plusieurs infections, y compris la VB, les IST et la MIP.
Prévention de la VB et de la MIP
Voici quelques conseils pour réduire votre risque de VB et de MIP :
Dépistage fréquent des IST
Un dépistage régulier permet une identification précoce et un traitement rapide des IST. Les partenaires sexuels doivent également se faire dépister, même sans symptômes.
Essayez les probiotiques vaginaux
Les probiotiques aident à rétablir l’équilibre des bonnes bactéries dans le microbiome vaginal et intestinal, prévenant les infections.
Évitez les douches vaginales
Les douches éliminent les bonnes bactéries et favorisent la propagation des infections dans le tractus génital. Lavez simplement la région vaginale à l’eau tiède.
Utilisez une protection pendant les rapports sexuels
Les préservatifs et une bonne hygiène des jouets sexuels réduisent le risque de transmission bactérienne.
Limitez vos partenaires sexuels
Réduire le nombre de partenaires sexuels diminue les expositions à des bactéries étrangères.
Conclusion
Bien que la VB et la MIP soient parfois négligées, elles peuvent entraîner de graves complications si elles ne sont pas traitées. En adoptant des pratiques de vie saines et en intégrant des probiotiques dans votre routine, vous pouvez protéger votre santé reproductive. N’attendez pas qu’une infection devienne sérieuse pour agir.
Prenez soin de votre santé dès aujourd’hui avec le soutien de FLORA™.

COMMANDER MAINTENANT
COMMANDER MAINTENANT


